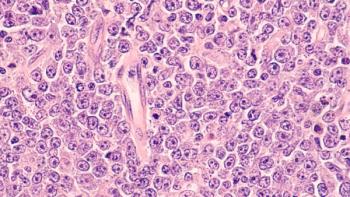
Image credit: David A Litman | stock.adobe.com

Integrate nutrition into the health care system with a proactive approach to chronic disease management

Integrate nutrition into the health care system with a proactive approach to chronic disease management

The application was previously granted fast track designation and orphan drug designation.

Investing in community relationships and health literacy are key steps pharmacists can take to improve equity.

pCR rates improve regardless of whether patients received full chemotherapy doses.

Trastuzumab deruxtecan and elacestrant represent important new treatment options.

The combination resulted in numerically longer OS compared with an NSAI alone.

Almost 80% of patients have now stopped treatment with ribociclib, but benefit persists and is greater than it was 6 months ago, according to the presenter.

As the use of sequencing, proteomics, and immunopeptidomics increases, more targets will also be discovered, as well as more biomarkers that predict responses to treatments.

Improvements in PFS were also seen among patients with brain metastases.

pCR rates were improved with the addition of pembrolizumab regardless of whether patients received the full chemotherapy doses.

MONARCH 3 final OS data show that the combination of abemaciclib and a NSAI in the first-line resulted in numerically longer OS compared to an NSAI alone.

Patients with an estrogen receptor measure greater than 8% and those with little to no TIL expression showed no benefit with the addition of nivolumab.

The investigational combination also delayed the median time to first chemotherapy in all age groups.

Biologic rationale, biomarker precision, and efficacy results in the biomarker-negative population all helped FDA officials decide the final indication.

Evidence has shown that reversing pro-cancer effects requires significant weight loss as well as substantial metabolic reprogramming.

Trastuzumab deruxtecan and elacestrant both represent important new treatment options for subgroups of patients with breast cancer.

The designation allows expedited development of ADP101 as a treatment for food allergy in children ages 4 to 17 with confirmed allergy to 1 or more of the 15 foods in the drug product.

Tirzepatide is already approved under the brand name Mounjaro (Lilly) to be used along with diet and exercise to improve blood sugar in adults with type 2 diabetes.

The approval marks the first new biologic treatment option for this patient population in nearly a decade.

Risk of long COVID was 3 times higher in those who had pre-existing conditions and a short sleep duration, compared to those with no pre-existing conditions and adequate sleep.

The approval marks the first and only once-daily target therapy for generalized myasthenia gravis for self-administration in this patient population.

If health care professionals want to increase access and care in these underrepresented communities, an important first step is also increasing the representation of those groups in health care itself.

The intravenous formulation of secukinumab is administered in monthly 30-minute, weight-based dosing and requires no pre-medication or lab monitoring.

Choice of therapy should be selected based on patient needs and conditions.

Although respondents reported no impacts on patient safety, workload significantly increased during the COVID-19 pandemic and led to major burnout challenges.
Axicabtagene ciloleucel achieved a complete metabolic response of 71% at 3 months versus 12% expected with standard of care among transplant ineligible patients with relapsed/refractory large B-cell lymphoma.

A supplemental New Drug Application will be submitted for roflumilast cream 0.05% for the treatment of mild to moderate atopic dermatitis in children 2 to 5 years of age.

Shared decision-making can be better incorporated into cardiovascular care guidelines by including decision aids, such as informational flyers or online tools to help patients.

Bispecific antibodies have 2 distinct binding domains, which interact with either CD3 on T cells or a tumor-associated antigen on the tumor cell surface.

As a once-daily oral treatment, orforglipron could help address barriers to injectable medications, such as semaglutide and liraglutide.